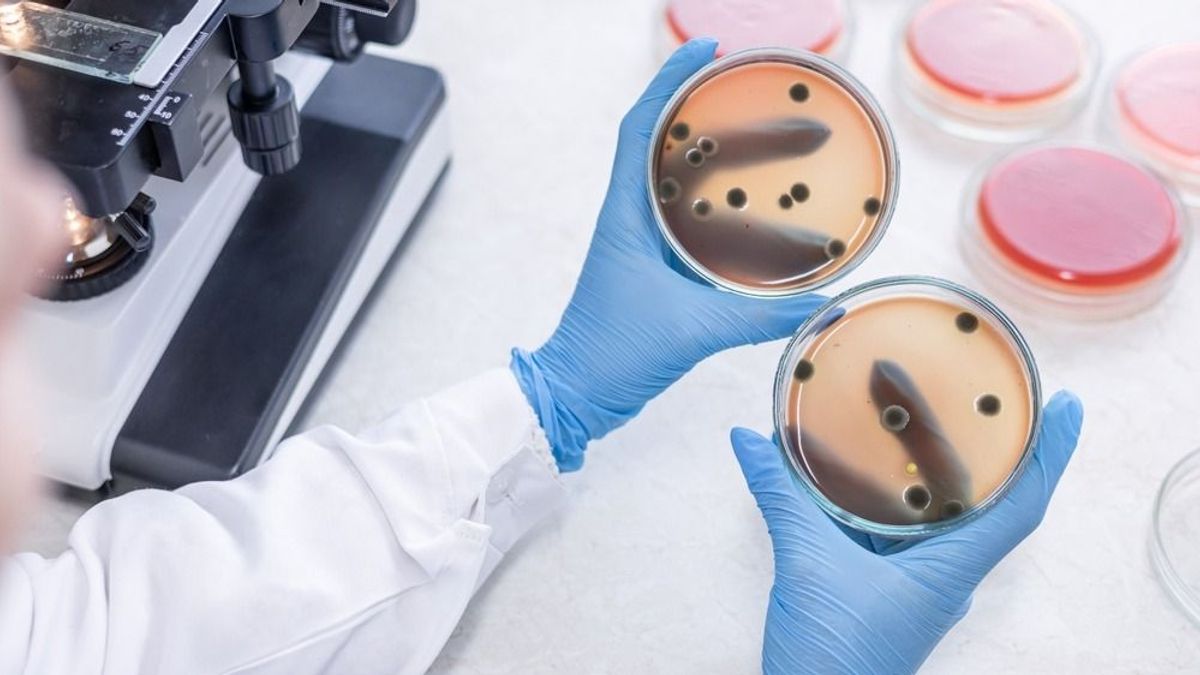

Meglepő, meddig életképesek a kórokozók a lakás különböző felületein, de van egy-két jó hírünk is
A vírusok meglepően sokáig fertőzhetnek bizonyos felületeken.
A vírusok meglepően sokáig fertőzhetnek bizonyos felületeken.